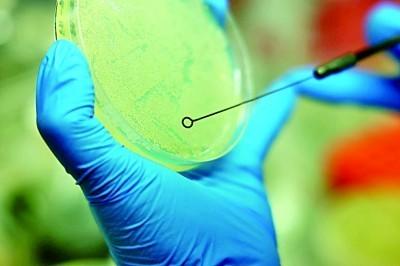

莫高窟坐落于河西走廊西部尽头的甘肃敦煌,是世界文化遗产,也是中华民族的文化艺术宝藏。图为9月26日拍摄的莫高窟窟区。

9月24日,敦煌研究院名誉院长樊锦诗(左一)、敦煌研究院党委书记赵声良(右一)和2024年刚入职敦煌研究院的钟芳蓉(右二),三代“莫高窟人”畅聊敦煌文化。

9月26日,敦煌研究院院长苏伯民(左)与同事一起在实验室观察实验数据。

7月25日,在莫高窟第55窟内,文物保护工作人员在修复壁画。
7月23日,在敦煌研究院保护研究所的实验室内,科研人员正在固体培养基中挑取微生物菌落。随着敦煌研究院文物保护研究的广度和深度不断扩展,涉及的学科也越来越多。

数字电影为游客欣赏敦煌艺术提供了全新的视觉体验。图为7月26日,游客在敦煌莫高窟数字展示中心欣赏球幕电影《梦幻佛宫》。

近年来,莫高窟已经逐渐形成风沙危害综合防护体系,有效减轻了风沙对石窟的影响。图为7月23日,在莫高窟的崖顶上,工作人员正在铺设草方格固沙。

7月25日,雕塑师付祥波在敦煌研究院雕塑室内为塑像临摹品上色。

7月24日,在莫高窟第341窟内,敦煌研究院文物数字化研究所的青年工作者们在做数字化采集。
5年前,习近平总书记来到敦煌莫高窟考察,并在敦煌研究院座谈会上发表重要讲话。他勉励敦煌文物工作者,努力把敦煌研究院建设成为世界文化遗产保护的典范和敦煌学研究的高地。9月11日,习近平总书记在考察甘肃天水麦积山石窟时,希望文物工作者赓续“莫高精神”,潜心为国护宝,为传承创新中华优秀传统文化、增强中华文化影响力作出更大贡献。
创建于公元4世纪的敦煌莫高窟,伴随着丝绸之路的兴盛,历经了千余年繁荣与沧桑。1944年,敦煌研究院前身“国立敦煌艺术研究所”成立,结束了敦煌石窟近400年无人管理、任凭损毁、屡遭破坏偷盗的历史。一梦入敦煌,一眼续千年。80年的漫长岁月里,敦煌文化和莫高窟的魅力,吸引着一代又一代年轻人远道而来。
莫高窟开窟造像的历史,是一部东西方文明交流的历史,更是一部中华民族谋求繁荣兴盛的历史。肃立在敦煌研究院常书鸿塑像前,樊锦诗深有感慨。1963年,樊锦诗从北京大学毕业后便加入敦煌文物研究所。光阴荏苒,作为“敦煌的女儿”,她在敦煌已经工作了61年。“没有强大的国力,便没有如今敦煌莫高窟的风采。从当年的举步维艰到今天的蓬勃发展,莫高窟走出甘肃,走出国门,走向世界,成为传播中华优秀传统文化的品牌。”樊锦诗在敦煌研究院建院80周年座谈会上感言。
对一个民族、一个国家而言,文物能够透显出其内在的文化精神。20世纪60年代初,国家开始了对莫高窟的全面保护和研究。1984年敦煌文物研究所扩建为敦煌研究院,研究力量进一步得到加强。进入21世纪,敦煌研究院在保护研究方面不断取得重大进展。今天,莫高窟作为珍贵的人类文化遗产,敦煌文化作为中华优秀传统文化的重要代表,吸引着全世界的目光。
敦煌文物保护,最主要的对象之一就是壁画。那些从十六国时期至元代持续绘制的壁画,在历经千年风霜后,面临起甲、空鼓、霉变、变色等病害影响。
莫高窟第55窟内,壁画修复师柴宗香一站就是一整天。于方寸之间施展妙手,让壁画枯木逢春。“我是真喜欢这些壁画啊!一想起自己的工作能延续文化瑰宝的生命,便充满成就感。”柴宗香感慨。
敦煌研究院院长苏伯民介绍:“我们持续对壁画病害进行修复,基本上抢救性的保护修复工作已经完成。现在开展的部分洞窟的修缮工程,只是针对局部问题。加上预防性保护体系的布设,我们对洞窟的健康状况持续监测,目前90%的洞窟非常稳定。”
在前辈探索壁画保护修复的基础上,年轻的莫高窟人通过文物数字化的研究与实践,让古老的文化瑰宝变得越来越年轻。
在莫高窟第341窟内,敦煌研究院文物数字化研究所的90后女孩儿吴绍侠与同事们一起对壁画进行数字化采集。谈起自己的工作,她满是自豪:“我们应用数字化技术留给后世相对完整的石窟壁画影像,使艺术珍品从洞窟走向大众,也让全世界更多人了解到中华优秀传统文化的魅力。”
敦煌莫高窟能够青春永驻,离不开一代又一代文物工作者的付出。80年来,他们扎根大漠之中,积淀形成了“坚守大漠、甘于奉献、勇于担当、开拓进取”的“莫高精神”,成为敦煌研究院80年薪火相传、生生不息的不竭源泉和强大动力。
“干着干着,这份事业就成了一种使命。”敦煌研究院保护研究所所长于宗仁感慨,“我们这些人都将是历史的过客,但莫高窟会一直在,守护她的人会永远年轻。”
“国家对我们的团队和工作给予了很大的认可,这也激励我们,要把莫高窟保护得更好,以高科技保护敦煌,以新理念传承文化。”敦煌研究院文物数字化研究所副所长丁晓宏说道。
毕业于北京大学考古文博学院的00后女孩儿钟芳蓉今年刚加入敦煌研究院。“能在这里传承中华文明传播中华文化,是我的荣幸。我们要拿好‘接力棒’,贡献青春力量。”她说。
时光,让敦煌这片土地逐渐古老,但有着1600余年历史的莫高窟,却永驻青春。新时代,古老的敦煌绽放出青春芳华,走进人们的心灵,走向世界的舞台。敦煌,这座艺术宝库的不朽价值,永远铭刻在历史深处。
(刘宇航 尚杰 王冰雅/撰文 刘宇航/摄影)




















































